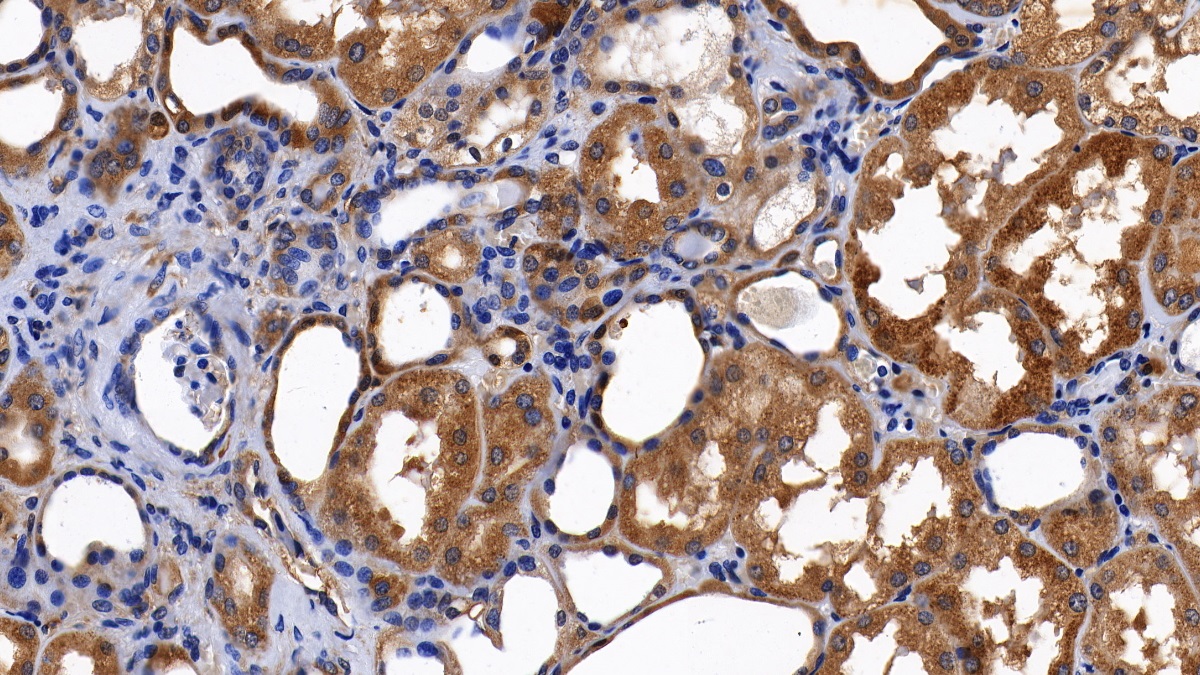

Polyclonal Antibody to Catalase (CAT) 

Overview
Properties
- Product No.PAC418Hu05
- Organism SpeciesHomo sapiens (Human) Same name, Different species.
- ApplicationsWB; IHC; FCM
If the antibody is used in flow cytometry, please check FCM antibodies.
Research use only - DownloadInstruction Manual
- CategoryEnzyme & KinaseMetabolic pathwayHepatology
- SourcePolyclonal antibody preparation, Host Rabbit
- Ig Type IgG, Potency n/a
- PurificationAntigen-specific affinity chromatography followed by Protein A affinity chromatography
- LabelNone
- Immunogen RPC418Hu05-Recombinant Catalase (CAT)
- Buffer Formulation0.01M PBS, pH7.4, containing 0.05% Proclin-300, 50% glycerol.
- TraitsLiquid, Concentration 500µg/mL
Sign into your account
Share a new citation as an author
Upload your experimental result
Review

Contact us
Please fill in the blank.
Specifity
The antibody is a rabbit polyclonal antibody raised against CAT. It has been selected for its ability to recognize CAT in immunohistochemical staining and western blotting.
Usage
Western blotting: 0.5-2μg/mL
Immunohistochemistry: 5-20μg/mL
Immunocytochemistry: 5-20μg/mL
Flow cytometry:20μg/ml;
Optimal working dilutions must be determined by end user.
Storage
Store at 4°C for frequent use. Stored at -20°C in a manual defrost freezer for two year without detectable loss of activity. Avoid repeated freeze-thaw cycles.
Stability
The thermal stability is described by the loss rate. The loss rate was determined by accelerated thermal degradation test, that is, incubate the protein at 37°C for 48h, and no obvious degradation and precipitation were observed. The loss rate is less than 5% within the expiration date under appropriate storage condition.
Organism Species More: Mus musculus (Mouse), Sus scrofa; Porcine (Pig)Giveaways
Increment services
-
 Antibody Labeling Customized Service
Antibody Labeling Customized Service
-
 Protein A/G Purification Column
Protein A/G Purification Column
-
 Staining Solution for Cells and Tissue
Staining Solution for Cells and Tissue
-
 Positive Control for Antibody
Positive Control for Antibody
-
 Tissue/Sections Customized Service
Tissue/Sections Customized Service
-
 Phosphorylated Antibody Customized Service
Phosphorylated Antibody Customized Service
-
 Western Blot (WB) Experiment Service
Western Blot (WB) Experiment Service
-
 Immunohistochemistry (IHC) Experiment Service
Immunohistochemistry (IHC) Experiment Service
-
 Immunocytochemistry (ICC) Experiment Service
Immunocytochemistry (ICC) Experiment Service
-
 Flow Cytometry (FCM) Experiment Service
Flow Cytometry (FCM) Experiment Service
-
 Immunoprecipitation (IP) Experiment Service
Immunoprecipitation (IP) Experiment Service
-
 Immunofluorescence (IF) Experiment Service
Immunofluorescence (IF) Experiment Service
-
 Buffer
Buffer
-
 DAB Chromogen Kit
DAB Chromogen Kit
-
 SABC Kit
SABC Kit
-
 Long-arm Biotin Labeling Kit
Long-arm Biotin Labeling Kit
-
 Real Time PCR Experimental Service
Real Time PCR Experimental Service
Citations
- Proteomic Analysis of Polymorphonuclear Neutrophils Identifies Catalase as a Novel Biomarker of Abdominal Aortic AneurysmAhajournals: source
- Phloroglucinol protects gastric mucosa against ethanol-induced injury through regulating myeloperoxidase and catalase activitiesPubMed: 20880383
- Antioxidant profile of salivary glands in high fat diet-induced insulin resistance ratsPubmed: 24106991
- Iodinated contrast media can induce long-lasting oxidative stress in hemodialysis patients.Pubmed: 24142649
- Grape seed extract and Zinc containing nutritional food supplement delays onset and progression of Streptozocin-induced diabetic cataract in Wistar ratsSpringer: Source
- 过氧化氢酶基因 389C>T多态位点在重庆汉族人群中的分布及其与噪音性耳聋的 关联研究Tmmu:Source
- Genetic polymorphisms (Pro197Leu of Gpx1, +35A/C of SOD1, PubMed: 26674569
- Antioxidant profile, carbonyl and lipid oxidation markers in the parotid and submandibular glands of rats in different periods of streptozotocin induced diabetesPubMed: 26143097
- Impact of morbid obesity and bariatric surgery on antioxidant/oxidant balance of the unstimulated and stimulated human salivaPubMed: 26608886
- КЛИНИЧЕСКОЕ ЗНАЧЕНИЕ ФАКТОРОВ КЛЕТОЧНОЙ РЕГУЛЯЦИИ И ФЕРМЕНТОВ АНТИОКСИДАНТНОЙ СИСТЕМЫ У ПАЦИЕНТОК РЕПРОДУКТИВНОГО ВОЗРАСТА С НАРУЖНЫМ ГЕНИТАЛЬНЫМ ЭНДОМЕТРИdocs:225188
- Comparison of Extracellular and Intracellular Blood Compartments Highlights Redox Alterations in Alzheimer's and Mild Cognitive Impairment Patients.pubmed:27748187
- Effect of Indole-3-carbinol and/or Metformin on Female Patients with Ulcerative Colitis (Premalignant Condition): Role of Oxidative Stress, Apoptosis and Proinflammatory Cytokinesjcrt:5
- Orthodontic treatment modifies the oxidant-antioxidant balance in saliva of clinically healthy subjects.pubmed:28242484
- Laminarin protects against hydrogen peroxide-induced oxidative damage in MRC-5 cells possibly via regulating NRF2pubmed:28785522
- Evaluation of ADMA, carbonyl groups, CAT and NKA in depressed patients with and without posttraumatic stress disorder.pubmed:28554099
- Biochemical and molecular alterations in freshwater mollusks as biomarkers for petroleum product, domestic heating oilPubmed:29660615
- Multi-biomarker responses after exposure to organophosphates chlorpyrifos in the freshwater mussels and snails10.1080:10807039.2018.1460800
- Effects of ginsenoside Rb1 on oxidative stress injury in rat spinal cords by regulating the eNOS/Nrf2/HO‑1 signaling pathwayPubmed:30116359
- A red pumpkin seed extract reduces melanosome transfer to keratinocytes by activation of Nrf2 signalingPubmed:30047218
- Cholecystectomy Patients with High Plasma Level of Catalase Have Significantly Lower Analgesia Requirement: A Prospective Study of Two Different …Pubmed: 30194197
- Plasma Catalase in Relation to Pain Following Midline Laparotomy: A Prospective Study of Patients with Benign Diseases and Patients with CancerPubmed: 30396975
- Effects of Tualang honey in modulating nociceptive responses at the spinal cord in offspring of prenatally stressed ratsDoi: 10.1016/j.joim.2018.12.002
- Protective effects of sulforaphane on diabetic retinopathy: activation of the Nrf2 pathway and inhibition of NLRP3 inflammasome formationPubmed: 30606939
- An in vitro protocol to study the effect of hyperglycemia on intracellular redox signaling in human retinal pigment epithelial (ARPE-19) cellsPubmed: 30628023
- Nitrotyrosine (NT), a Nitrosative Stress Biomarker, Plasma Concentrations in Gallstone Disease and Cancer PatientsPubmed: 30711961
- Rectus Sheath Block (RSB) Analgesia Could Enhance Significantly the Patient Satisfaction Following Midline Laparotomy in Benign Disease and in Cancer: A …Pubmed: 30842172
- MicroRNA‑21 contributes to the puerarin‑induced cardioprotection via suppression of apoptosis and oxidative stress in a cell model of ischemia/reperfusion injuryPubmed: 31115556
- Selected elements of extracellular matrix of the skin in diabetes and insulin resistancePubmed: 31146169
- European Journal of Biomedical AND Pharmaceutical sciences
- The Rectus Sheath Block (RSB) Analgesia Following Laparotomy Could Affect Malonidialdehyde (MDA) Concentrations in Benign Disease and CancerPubmed: 31892574
- A Machine Learning-driven Study Indicates Emodin Improves Cardiac Hypertrophy by Modulation of Mitochondrial SIRT3 SignalingPubmed: 32135248
- Arachidonic Acid as an Early Indicator of Inflammation during Non-Alcoholic Fatty Liver Disease DevelopmentPubmed: 32751983
- AMELIORATIVE EFFECT OF AQUEOUS EXTRACT OF HIBISCUS SABDARIFFA (ROSELLE) ON SALT-INDUCED HYPERTENSION IN WISTAR RATS
- In Vitro Cell Culture Study of Anticholesterol and Antioxidant Activities of Myrmecodia platytyrae (MyP) Extract in WRL-68 Cells
- Lutein reverses hyperglycemia-mediated blockage of Nrf2 translocation by modulating the activation of intracellular protein kinases in retinal pigment epithelial (ARPE …
- Plasma catalase (CAT) levels in gallstone disease: Cholecystectomy patients with high plasma levels of CAT have significantly lower number of analgesic …
- Effects of Tualang Honey on Pain Behaviour and Oxidative Stress in the Thalamus of Prenatally Stressed Rat Offspring
- Toxic Trace Metals and Pathological Changes in Organs of Rats Fed with Extract of Polluted Grasses
- Effects of Ganoderma lucidum polysaccharides on different pathways involved in the development of spinal cord ischemia reperfusion injury: biochemical ¡33689849
- Mechanisms of Trx2/ASK1-Mediated Mitochondrial Injury in Pemphigus Vulgaris33763469
- Attenuation of Oxidative Stress and Inflammatory Response by Chronic Cannabidiol Administration Is Associated with Improved n-6/n-3 PUFA Ratio in the White and?¡34064937
- Lycium barbarum polysaccharides attenuate cardiovascular oxidative stress injury by enhancing the Keap1/Nrf2 signaling pathway in exhaustive exercise rats34278476
- Associations of Antioxidant Enzymes with the Concentration of Fatty Acids in the Blood of Men with Coronary Artery Atherosclerosis34945751
- Plasma Concentration of the Lipid Peroxidation (LP) Biomarker 4-Ηydroxynonenal (4-HNE) in Benign and Cancer PatientsPubmed:35241533
- α-Lipoic acid ameliorates inflammation state and oxidative stress by reducing the content of bioactive lipid derivatives in the left ventricle of rats fed a high-fat dietPubmed:35569738
- Bio-Evaluation of the Wound Healing Activity of Artemisia judaica L. as Part of the Plant's Use in Traditional Medicine; Phytochemical, Antioxidant, Anti-Inflammatory …Pubmed:35204215